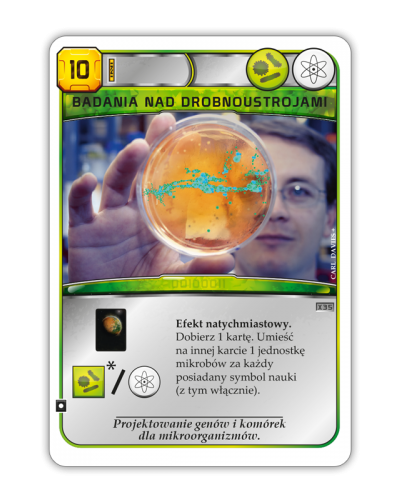
Terraformacja Marsa Zestaw dodatkowy #6 i #7 (5 kart)

- Stan: W magazynie
- Czas wysyłki: 2-3 dni w dni robocze
- Model: Terraformacja Marsa Zestaw dodatkowy #6 i #7 (5 kart)
Opis
Uwaga! To nie jest samodzielna gra! Do rozgrywki wymagana jest podstawowa wersja gry: Terraformacja Marsa (edycja Gra Roku).
Przegląd najnowszych projektów, w które warto zainwestować
Zwiększ swoje możliwości inwestowania w wielkoskalowe projekty kosmiczne, połącz rozwój z pozyskiwaniem cennego materiału biologicznego i wykorzystaj nowoczesne sporty outdoorowe jako źródło zarobku. Terraformacja Marsa: Zestaw dodatkowy #6 i #7 to 5 nowych kart projektów, które czekają na śmiałych inwestorów!
Czym jest Terraformacja Marsa?
To rozbudowana, wielowymiarowa gra strategiczna związana z tematem kolonizacji kosmosu. Uczestnicy wcielają się w przedstawicieli największych ziemskich korporacji, które podjęły się wysiłku zmiany Marsa w planetę zdatną do życia. Nie kieruje nimi jednak wyłącznie dobro ludzkości – inwestując w rozmaite projekty biznesmeni będą starali się jak najlepiej wykorzystać dostępne możliwości, by zmaksymalizować zyski i odtrąbić spektakularny sukces.
Zawartość pudełka:
- 5 kart

Specyfikacja
| Informacje | |
| Wydawca | Rebel |
| Wersja językowa | Polska |
| Przedział wiekowy | 12+ |
| Liczba graczy | 1-5 |
| Długość rozgrywki | ok. 90-120 minut |
| Wymagania | Do rozgrywki wymagana jest podstawowa wersja gry: Terraformacja Marsa (edycja Gra Roku). |
| Kod produktu | 5902650617957 |
| Wymiary pudełka | 9.5 x 6.5 x 1 cm |
| Informacje dotyczące bezpieczeństwa | Posiada logo CE. Nie nadaje się dla dzieci w wieku poniżej 3 lat. Zawiera małe elementy - ryzyko zadławienia. |




